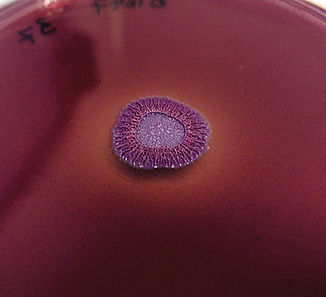

top of page


The Microbiologist's Handbook

Welcome to The Microbiologist's Handbook
Your go-to app for educational microbiology content including pre-set lab calculators, experimental protocols, and exclusive discounts on lab equipment.
Download the free app here
| Pre-set calculators | Protocols | Discount codes

Congo red agar assay

Bacterial two-hybrid assay
Swimming motility assay
Our Mission
At The Microbiologist's Handbook, we are passionate about providing valuable resources and tools for microbiologists. Our app aims to assist learning, streamline lab processes and support scientific discoveries. The app has been designed to help any microbiologist, whether that's a student taking their first steps in the lab, or a seasoned researcher who just wants to speed up everyday lab calculations.



Dedicated to advancing microbiology knowledge, our app offers a comprehensive collection of protocols and pre-set calculators.
bottom of page
